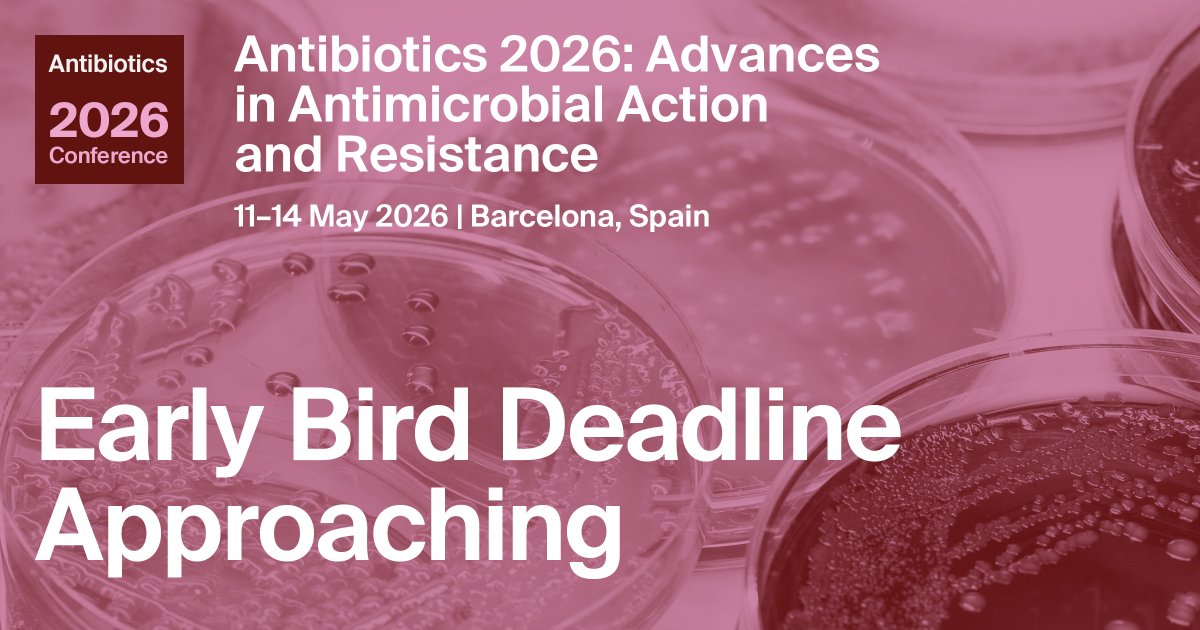
sciforum's tweet image. ⌛Only 10 Days Left to Save on #Antibiotics2026 with #EarlyBird Rates!

~ Four days of cutting-edge research on #AMR, #ethnopharmacology, #drugdiscovery, #antimicrobialstewardship, and #OneHealth approaches

~ A world-class speaker line-up, including keynotes Dr. @mcastanheirajmi
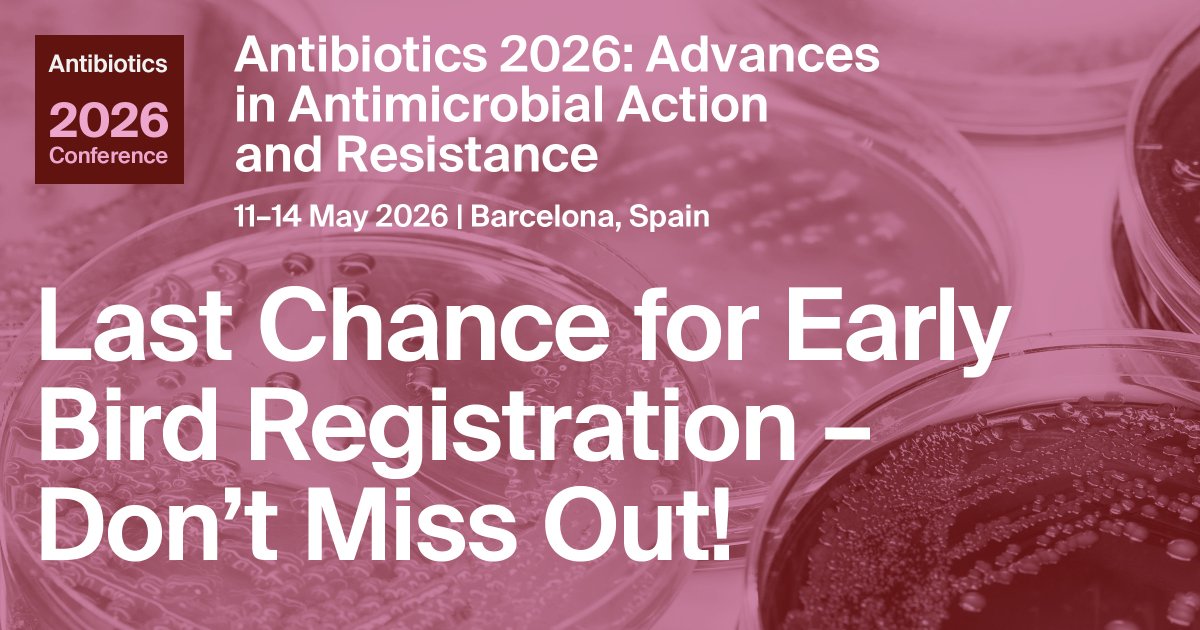
sciforum's tweet image. 🚨 Only 3 Days Left to Save 🚨

#EarlyBird registration for #Antibiotics2026 ends this Sunday! This is your last chance to join a truly global conversation on the future of antimicrobial science, at the best possible rate 💸

Join researchers, clinicians, and innovators from

#earlybird search results
Super Early-Bird tickets for #VAC2026 are available for a limited time. Join us on Friday, 9 October 2026 at the QEII Centre, Westminster, London for a full day of industry insight, networking, and expert speakers. Register now: vacevents.com/registration/ #EarlyBird #LondonEvents

Save £50 on IOSH Managing Safely – Summer Dates ☀️ Managing people means managing risk. Join our #IOSH Managing Safely Course and gain the confidence to lead safely and legally. 🐦 £399 + VAT | ⏳ Limited places 👉 Book now: bit.ly/3xP8Zhs #EarlyBird #SafetyLeadership

🚨 Just 3 Days Left! ⏳ Early Bird for APICON 2027, Gurgaon ends 30 April! 🎟️ Grab the best rates now 📅 18–21 Feb 2027 📲 Register today #APICON2027 #3DaysToGo #EarlyBird #DoctorsOfIndia #RegisterNow

3 AM grind is real! Pushing limits at the gym, even when legs feel like jelly. This is that good work. #GymLife #EarlyBird #NoExcuses
🚨 Save £50 on IOSH Managing Safely – July & August Better decisions. Fewer incidents. Stronger leadership. 🐦Early Bird: Only £399 + VAT Limited places available. UK Dates, book now:👉 bit.ly/3xP8Zhs #IOSHManagingSafely #SafetyTraining #EarlyBird

Ughh na zo’n fijn weekend valt dit toch echt effe vies tegen zeg 😑 had ik eigenlijk grootste gedeelte van de dag bhv brand communicatie & protocollen training, hebben we teveel zieken en gaat dat helaas niet door 🙁 nou koffie dan maar? #goedemorgen #earlybird

The week has officially started. 6.2 miles of pure headspace under the moonlight, this serious moonlight. #Running #10k #EarlyBird #MoonlightRun

Folks, if you’re considering sponsoring #CORL2026, this is your last call to get in with #EarlyBird pricing (Apr 15 deadline), and before we run out of booth space at the venue!! Please contact [email protected] to participate.
Good morning #Brekko 👊🏿 Siku Ingine Tunashukuru 🙏🏿 Tukizidi kusaka #EarlyBird Locked 🔒
🚨 Last call for the DRAG 6 Early Bird event! 👀 Don't miss your chance to split 166 DRAG 6 prizes. ⏳ Ends April 7 — head to the link in bio now and join before it's gone. #VOOPOO #VOOPOODRAG #EarlyBird #DRAG6 #Split166DRAG6Prize

Here’s Your Early Bird Guide to Disney Springs! mickeyblog.com/2026/04/17/her… #DisneySprings #DisneyWorld #EarlyBird #guide
Early Bird Closing Soon! Join @Obesity2026 📅 Oct 29–30, 2026 📍 Holiday Inn Resort Orlando – Lake Buena Vista 🎯 Limited-time discounted registration ⏳ Don’t wait—secure your spot today! 🔗 obesity-congress.com/registration.p… #ISOWM2026 #ObesityConference #EarlyBird #RegisterNow

Early Birds catch the rewards!. Sign up now to snag a FREE LUCK BOOSTER and join a community that trades strategy on our NFT Marketplace (marketplace.boostlottery.io) . Don't miss our upcoming TGE and the first massive monthly draws! 🚀🎰 #EarlyBird

⏰ Reminder: Early Bird Tickets Are Still Available! 🎟️ Don’t miss out on your chance to attend PyCon Africa 2026 in Kampala (Oct 7–11) 🌍 🐍 Secure your discounted tickets before they’re gone! #PyConAfrica2026 #EarlyBird #PythonCommunity #Kampala

The Malkajgiri Municipal Corporation (#MMC) has introduced an #EarlyBird discount scheme, offering a 5% rebate on #propertytax payments made before April 30 for the fiscal year 2026–27. #Malkajgiri telanganatoday.com/malkajgiri-mun…
Good morning Team #Brekko 👊🏿 Brand New Week Tunashukuru 🙏🏿 Ikue blessed tukizidi ku Hustle #EarlyBird
Save £50 on IOSH Managing Safely – Summer Dates ☀️ Managing people means managing risk. Join our #IOSH Managing Safely Course and gain the confidence to lead safely and legally. 🐦 £399 + VAT | ⏳ Limited places 👉 Book now: bit.ly/3xP8Zhs #EarlyBird #SafetyLeadership

🚨 Just 3 Days Left! ⏳ Early Bird for APICON 2027, Gurgaon ends 30 April! 🎟️ Grab the best rates now 📅 18–21 Feb 2027 📲 Register today #APICON2027 #3DaysToGo #EarlyBird #DoctorsOfIndia #RegisterNow

Super Early-Bird tickets for #VAC2026 are available for a limited time. Join us on Friday, 9 October 2026 at the QEII Centre, Westminster, London for a full day of industry insight, networking, and expert speakers. Register now: vacevents.com/registration/ #EarlyBird #LondonEvents

📈 Pendant que certains hésitent, d’autres construisent déjà leur avance. Le timing change tout. 🚀 #Mytier #EarlyBird #Wealth #DigitalFuture #Momentum #mytie
Early Bird Closing Soon! Join @Obesity2026 📅 Oct 29–30, 2026 📍 Holiday Inn Resort Orlando – Lake Buena Vista 🎯 Limited-time discounted registration ⏳ Don’t wait—secure your spot today! 🔗 obesity-congress.com/registration.p… #ISOWM2026 #ObesityConference #EarlyBird #RegisterNow

Good morning #Brekko 👊🏿 Siku Ingine Tunashukuru 🙏🏿 Tukizidi kusaka #EarlyBird Locked 🔒
🎯 Alpha 🎯 $FOX 🔗 : 0x899899d4f7fde39ce8c784348a547b78da5d4444 💵 MC : 4.32K 🔮 AI :Told you FOX was a winner! 🚀💰 #EarlyBird 🤖 Check 👉 OKAI.HK/ALpha 💎

🔥 Early Bird: Summer IOSH Managing Safely 🔥 Managers & supervisors: train this summer for £399 + VAT and save £50. Gain practical H&S skills, legal confidence & an IOSH‑recognised certificate. 👉 Book early: bit.ly/3xP8Zhs #IOSH #EarlyBird #Managers"

MS2133 USB 3.0 HD Video Capture + HD2.0 Loop Out + Mixing Processing Chip Supports Audio ARC Multiple types of audio mix functions High Definition Video Capture Card Live Video Streaming #UVC #EarlyBird #4K60

Plus or Pro? Haven Plus = $3.99/mo (ad-free + shelves). Haven Pro = $7.99/mo (AI features + imports + priority support). Both locked in forever before May 1. ✨ myreadershaven.com #MyReadersHaven #EarlyBird

Get Equipped AI Summit™ 2026 Nov 13–14 · Fort Lauderdale Virtual $97 · In-Person $397 · VIP $697 Can't afford it? Apply for the Startup Grant attend FREE. Closes June 15th. 🔗 enilramcreative.com/getequippedais… #GetEquippedAISummit #EarlyBird #AIForBusiness



3 Days to Go ⏳ Early Bird Registration is closing soon! Don’t miss your chance to grab the best deal. Secure your spot before it’s gone! 🎟️ #EarlyBird #LastChance #RegisterNow

🚨 Save £50 on IOSH Managing Safely – July & August Better decisions. Fewer incidents. Stronger leadership. 🐦Early Bird: Only £399 + VAT Limited places available. UK Dates, book now:👉 bit.ly/3xP8Zhs #IOSHManagingSafely #SafetyTraining #EarlyBird

🌞 Summer IOSH Managing Safely – Early Bird Now Live! If you manage people, this course protects you. ✅ Practical risk management ✅ Legal awareness ✅ IOSH certificate 🐦 £399 + VAT (Save £50) 👉 Book now: bit.ly/3xP8Zhs #IOSH #ManagingSafely #EarlyBird

Good morning Team #Brekko 👊🏿 Brand New Week Tunashukuru 🙏🏿 Ikue blessed tukizidi ku Hustle #EarlyBird
Can't believe how late it is past my bedtime! Def need to catch some Zzz's bc I have an early start tomorrow. Hoping for some sweet dreams to recharge. Wishing everyone a peaceful night!Sleep tight! See you all in the morning! #Goodnight #SweetDreams #EarlyBird #SleepyHead
Our latest #Earlybird brings another new title with: Endo and Kobayashi Live! The Latest on Tsundere Villainess Lieselotte Collection Blu-Ray anime-on-line.com/3148-early-bir…

#EARLYBIRD 아시아 최초 대규모 개인전, 데이미언 허스트 전시 얼리버드 예매를 시작합니다! 《데이미언 허스트: 진실은 없어 그러나 모든 것은 가능하지》전 얼리버드 예매 ◼ 예매기간: 2026. 2. 23.(월) 18:00 ~ 3. 19.(목) 23:50 ◼ 관람기간: 2026. 3. 20.(금) ~ 4. 5.(일) ◼ 얼리버드 가격:


⏰ Reminder: Early Bird Tickets Are Still Available! 🎟️ Don’t miss out on your chance to attend PyCon Africa 2026 in Kampala (Oct 7–11) 🌍 🐍 Secure your discounted tickets before they’re gone! #PyConAfrica2026 #EarlyBird #PythonCommunity #Kampala

Our last #Earlybird for the time being has now changed to: Fate/Grand Order Absolute Demonic Front: Babylonia Part 2 - Collector's Edition Blu-Ray anime-on-line.com/3148-early-bir…

**BREAKING NEWS** We have decided to EXTEND our #Earlybird ticket prices until 1st April 2026!! So why not get yours now for the party of the year @the_grandstation with a 3 course meal, celebrity guests and performances from @seanheydon and @the_ac30s_band Get your individual

Early Birds catch the rewards!. Sign up now to snag a FREE LUCK BOOSTER and join a community that trades strategy on our NFT Marketplace (marketplace.boostlottery.io) . Don't miss our upcoming TGE and the first massive monthly draws! 🚀🎰 #EarlyBird

⌛Only 10 Days Left to Save on #Antibiotics2026 with #EarlyBird Rates! ~ Four days of cutting-edge research on #AMR, #ethnopharmacology, #drugdiscovery, #antimicrobialstewardship, and #OneHealth approaches ~ A world-class speaker line-up, including keynotes Dr. @mcastanheirajmi
🚨 Offre early bird jusqu’au 20/02 – minuit ! 🐦 290 € pour exposer à la 13ᵉ édition du Salon Effervescence 95 🔥 📅 19 mai 2026 📍 Hippodrome d'Enghien-Soisy-Eaubonne 👉saloneffervescence.fr/95/tarifs-des-… #Exposants #PME #EarlyBird #ValdOise @PKuchly57 @effervescence95 @CCI_Paris_IdF



Our latest #Earlybird has now changed, bringing more Fate goodness with: Fate/Grand Order Absolute Demonic Front: Babylonia Part 1 Collector's Edition Blu-Ray anime-on-line.com/3148-early-bir…

Ughh na zo’n fijn weekend valt dit toch echt effe vies tegen zeg 😑 had ik eigenlijk grootste gedeelte van de dag bhv brand communicatie & protocollen training, hebben we teveel zieken en gaat dat helaas niet door 🙁 nou koffie dan maar? #goedemorgen #earlybird

Happy Saturday Everybody, Try to forget the rain, and whatever weather you are experiencing, wherever you are in the world. Have joy - laugh - and enjoy. #WritingCommunity #saturdaymorning #earlybird #SaturdayThoughts #GoodMorning

Happy Saturday - May your day be full of good surprises - scattered with smiles, and easy laughter. Have an awesome day. #WritingCommunity #earlybird #saturdaymorning #SaturdayThoughts #GoodMorning

Early Bird🚨 DRAG 6 Is Coming Be the first. Be the legend. Enter our official website — join the DRAG 6 Early Bird event now and get a chance to 𝙎𝙥𝙡𝙞𝙩 𝟭𝟲𝟲 𝘿𝙍𝘼𝙂 𝟲 𝙋𝙧𝙞𝙯𝙚𝙨! #VOOPOO #VOOPOODRAG #EarlyBird #DRAG6 #Split166DRAG6Prizes

Another week, another #Earlybird deal! This week save on: When Will Ayumu Make His Move? Collection Blu-Ray anime-on-line.com/3148-early-bir…

Don’t miss out on savings! 🎉 Enjoy 10–15% OFF Session 2 fees with our Earlybird Discount. 🗓 Register before: 7th March 2026 🚀 Session starts: 30th March 2026 Register early, save more, and start strong! #EarlyBird #DiscountAlert #LearnFrench #LanguageSchool #AccraEvents

🚨 Only 3 Days Left to Save 🚨 #EarlyBird registration for #Antibiotics2026 ends this Sunday! This is your last chance to join a truly global conversation on the future of antimicrobial science, at the best possible rate 💸 Join researchers, clinicians, and innovators from
The hottest night of the year is calling. 🥂✨ Grab your ASN Awards tickets now at ASNAwards.com and use code EARLYBIRD for 25% off! 🎟️🔥 Don’t wait: everyone needs a ticket to the main event. See you there! 🏆 #ASNAWARDS #EarlyBird #AwardsSeason #RedCarpetReady

🚨 Last call for the DRAG 6 Early Bird event! 👀 Don't miss your chance to split 166 DRAG 6 prizes. ⏳ Ends April 7 — head to the link in bio now and join before it's gone. #VOOPOO #VOOPOODRAG #EarlyBird #DRAG6 #Split166DRAG6Prize

Something went wrong.
Something went wrong.
United States Trends
- 1. OPEC N/A
- 2. #lovelygrey N/A
- 3. Rob Thomson N/A
- 4. Don Mattingly N/A
- 5. Good Tuesday N/A
- 6. Fauci N/A
- 7. State of Collapse N/A
- 8. The UAE N/A
- 9. Kevin Long N/A
- 10. David Morens N/A
- 11. Ted Lasso N/A
- 12. Mourinho N/A
- 13. Kid Rock N/A
- 14. #LaSayonaExtorsionadora N/A
- 15. The United Arab Emirates N/A
- 16. #NationalSuperheroDay N/A
- 17. Topper N/A
- 18. Quality Learing Center N/A
- 19. #YouManiacSeriesQ9 N/A
- 20. Roseanne N/A










































































